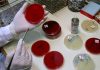
Effective Strategies for Responsible Antibiotic use Effective Strategies for Responsible Antibiotic use

Election of readers
All News
All News
Angola
overcast clouds
28.3
°
C
28.3
°
28.3
°
47 %
1.6kmh
98 %
Sun
28
°
Mon
28
°
Tue
22
°
Wed
25
°
Thu
24
°